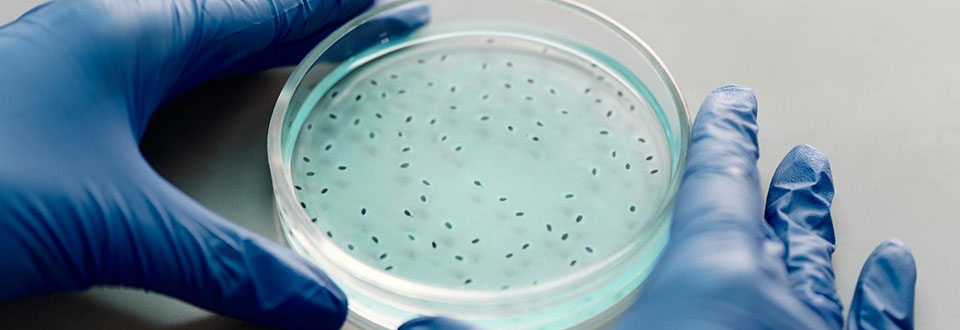
Quando si collabora i cervelli si allineano

Il terribile botulismo - che può uccidere perché le tossine batteriche che lo originano bloccano il rilascio dei neurotrasmettitori a livello delle terminazioni nervose, provocando una paralisi muscolare - può far danni anche quando la tossina è in dosi talmente basse da non determinare la patologia. Anche in quantità minima, infatti, le tossine botuliniche possono interferire con i meccanismi di difesa dell’intestino, favorendo così le infezioni da batteri patogeni come Salmonella e Shigella.
È a queste conclusioni che è giunto uno studio condotto da ricercatori del Dipartimento di Scienze Biomediche dell’Università di Padova e pubblicato in «Science Advances».
Sotto la lente dei ricercatori i casi verificatesi l’estate scorsa in Calabria ed in Sardegna e in particolare i pazienti che avevano segnalato solo sintomi lievi prevalentemente a carico dell'intestino: «Sono considerati generalmente clinicamente irrilevanti - dice Cesare Montecucco, co-corresponding author della ricerca - . Abbiamo invece dimostrato che dosi bassissime di tossina botulinica possono favorire infezioni intestinali dovute a batteri patogeni presenti nell'intestino in quantità così basse, da non provocare normalmente alcuna malattia”.
«Le tossine botuliniche sono in grado di entrare nei neuroni del sistema nervoso enterico alterando funzioni fondamentali per la difesa della mucosa intestinale», aggiunge Ornella Rossetto, dip di Scienze biomediche dell’Università di Padova e co-corresponding author della ricerca .
«Questi risultati portano anche a una revisione importante del modello tradizionale della patogenesi del botulismo – conclude Federico Fabris, primo autore dello studio -. Finora l’intestino era considerato principalmente come una porta d’ingresso della tossina nel circolo sanguigno, necessaria a raggiungere il sistema nervoso periferico. Il nostro studio dimostra invece che l’intestino, e in particolare il sistema nervoso enterico, rappresenta il primo sito d’azione funzionale della tossina».